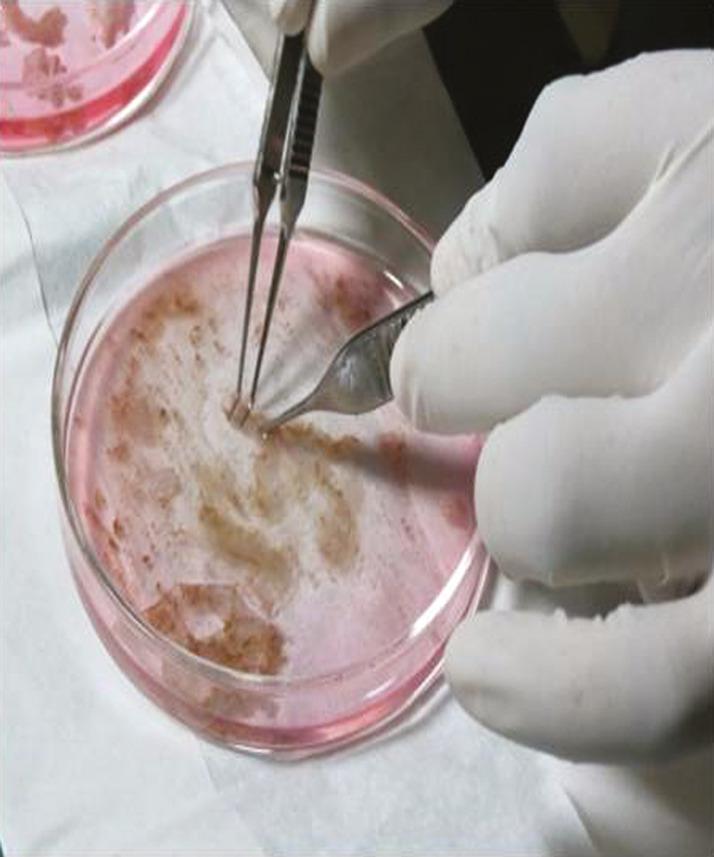
https://cdn.ncbi.nlm.nih.gov/pmc/blobs/b814/7335465/784e84beac60/JCAS-13-38-g003.jpg

自体破碎滤泡真皮移植物联合表皮细胞悬液治疗慢性难愈性腿部溃疡
Autologous Smashed Follicular Dermal Graft with Epidermal Cell Suspension in Chronic Nonhealing Leg Ulcers.
作者信息
Nagaraju Umashankar, Kashyap Pranami, Raveendra Leena
机构信息
Department of Dermatology, Venereology and Leprology, RajaRajeswari Medical College and Hospital, Bengaluru, Karnataka, India.
出版信息
J Cutan Aesthet Surg. 2020 Jan-Mar;13(1):38-42. doi: 10.4103/JCAS.JCAS_105_19.
Wound healing is a multifaceted process. Restoration of the epithelium may occur either by migration of activated epithelial keratinocytes from the adjoining epithelium or by centrifugal migration of putative stem cells found in the bulge region of the hair follicle. Dermal collagen and glycosaminoglycans also play a key role in laying down the scaffold for vascular in-growth and population of the matrix with host fibroblasts. Despite the availability of a wide range of treatment modalities, chronic nonhealing leg ulcers remain a therapeutic challenge and cause significant patient morbidity. Hence, there is a further need to develop novel techniques which would be effective, safe, easily available, and affordable for the patient.
伤口愈合是一个多方面的过程。上皮的修复可通过活化的上皮角质形成细胞从相邻上皮迁移,或通过在毛囊隆突区发现的假定干细胞的离心迁移来实现。真皮胶原蛋白和糖胺聚糖在为血管向内生长和宿主成纤维细胞填充基质奠定支架方面也起着关键作用。尽管有多种治疗方式可供选择,但慢性不愈合腿部溃疡仍然是一个治疗挑战,并导致患者出现严重的发病情况。因此,进一步需要开发对患者有效、安全、易于获得且负担得起的新技术。